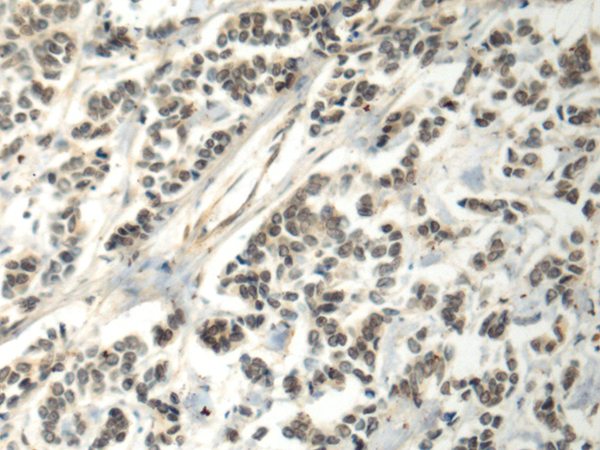

中文名稱:兔抗CCNA1多克隆抗體
英文名稱: Anti-CCNA1 rabbit polyclonal antibody
別 名: CT146
抗 原: CCNA1
儲(chǔ) 存: 冷凍(-20℃)
宿 主: Rabbit
反應(yīng)種屬: Human, Mouse, Rat
相關(guān)類別: 一抗
標(biāo) 記 物: Unconjugate
克隆類型: rabbit polyclonal
技術(shù)規(guī)格
|
Background: |
The protein encoded by this gene belongs to the highly conserved cyclin family, whose members are characterized by a dramatic periodicity in protein abundance through the cell cycle. Cyclins function as regulators of CDK kinases. Different cyclins exhibit distinct expression and degradation patterns which contribute to the temporal coordination of each mitotic event. The cyclin encoded by this gene was shown to be expressed in testis and brain, as well as in several leukemic cell lines, and is thought to primarily function in the control of the germline meiotic cell cycle. This cyclin binds both CDK2 and CDC2 kinases, which give two distinct kinase activities, one appearing in S phase, the other in G2, and thus regulate separate functions in cell cycle. This cyclin was found to bind to important cell cycle regulators, such as Rb family proteins, transcription factor E2F-1, and the p21 family proteins. Multiple transcript variants encoding different isoforms have been found for this gene. |
|
Applications: |
ELISA, IHC |
|
Name of antibody: |
CCNA1 |
|
Immunogen: |
Fusion protein of human CCNA1 |
|
Full name: |
cyclin A1 |
|
Synonyms: |
CT146 |
|
SwissProt: |
P78396 |
|
ELISA Recommended dilution: |
5000-10000 |
|
IHC positive control: |
Human breast cancer and Human esophagus cancer |
|
IHC Recommend dilution: |
50-200 |

購(gòu)物車
幫助
021-54845833/15800441009
